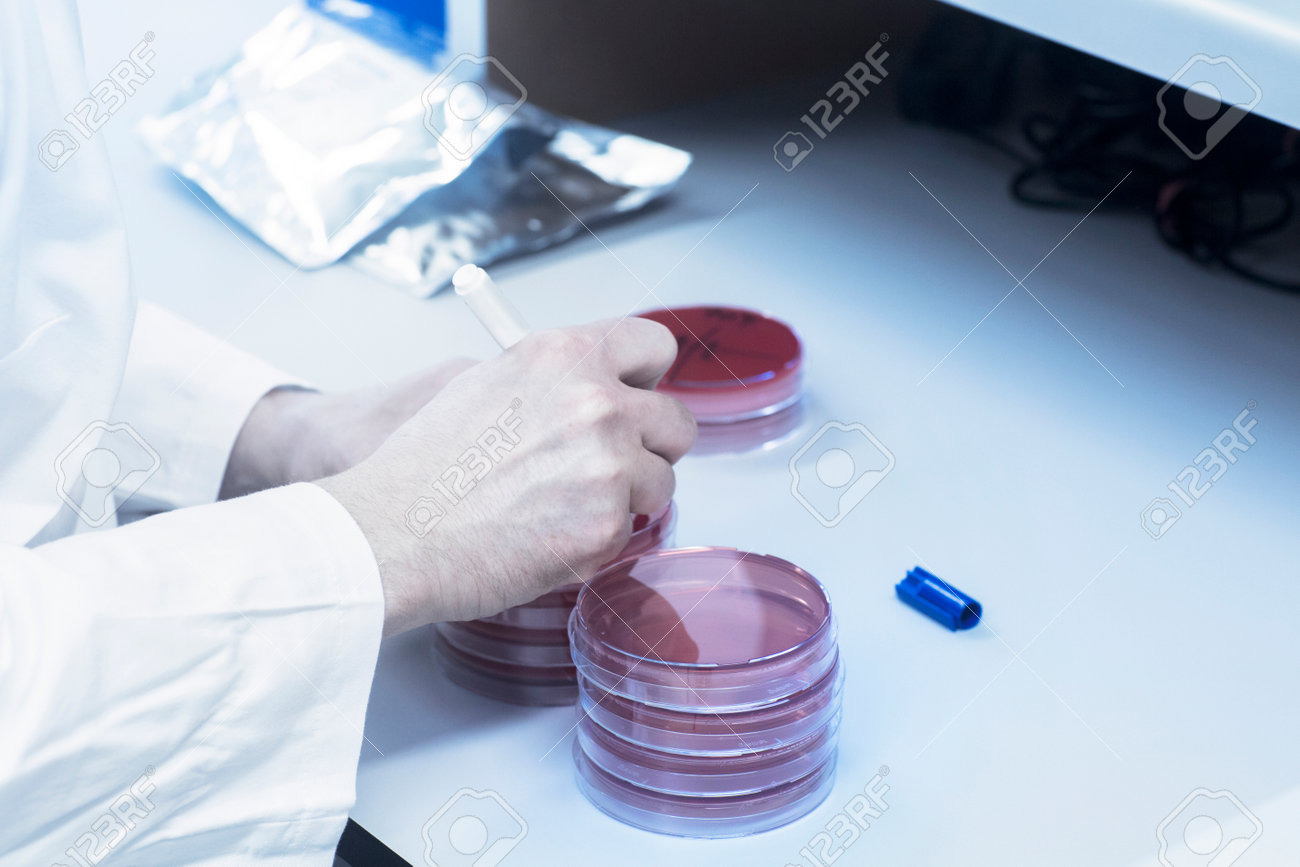
etiam-dictum-ipsum-a-felis

Download
Close
Автор:
id:
Ключевые слова:
analysing, analyzing, animal body part, animal hand, animal limb, animal medicine, closeup, coat, cropped, diagnosis, focus on foreground, hand, healthcare, healthcare and medicine, human hand, identity, illness, indoors, lab coat, lab technician, laboratory, laboratory equipment, laboratory technician, marking, medicine, medicines, numeral, one person, orthographic symbol, outerwear, part of, petri dish, real people, research and development, research facility, sample, sampling, science, science occupation, scientific equipment, scientist, selective focus, september 2016 release, sitting, symbol, unwell, wearing,





